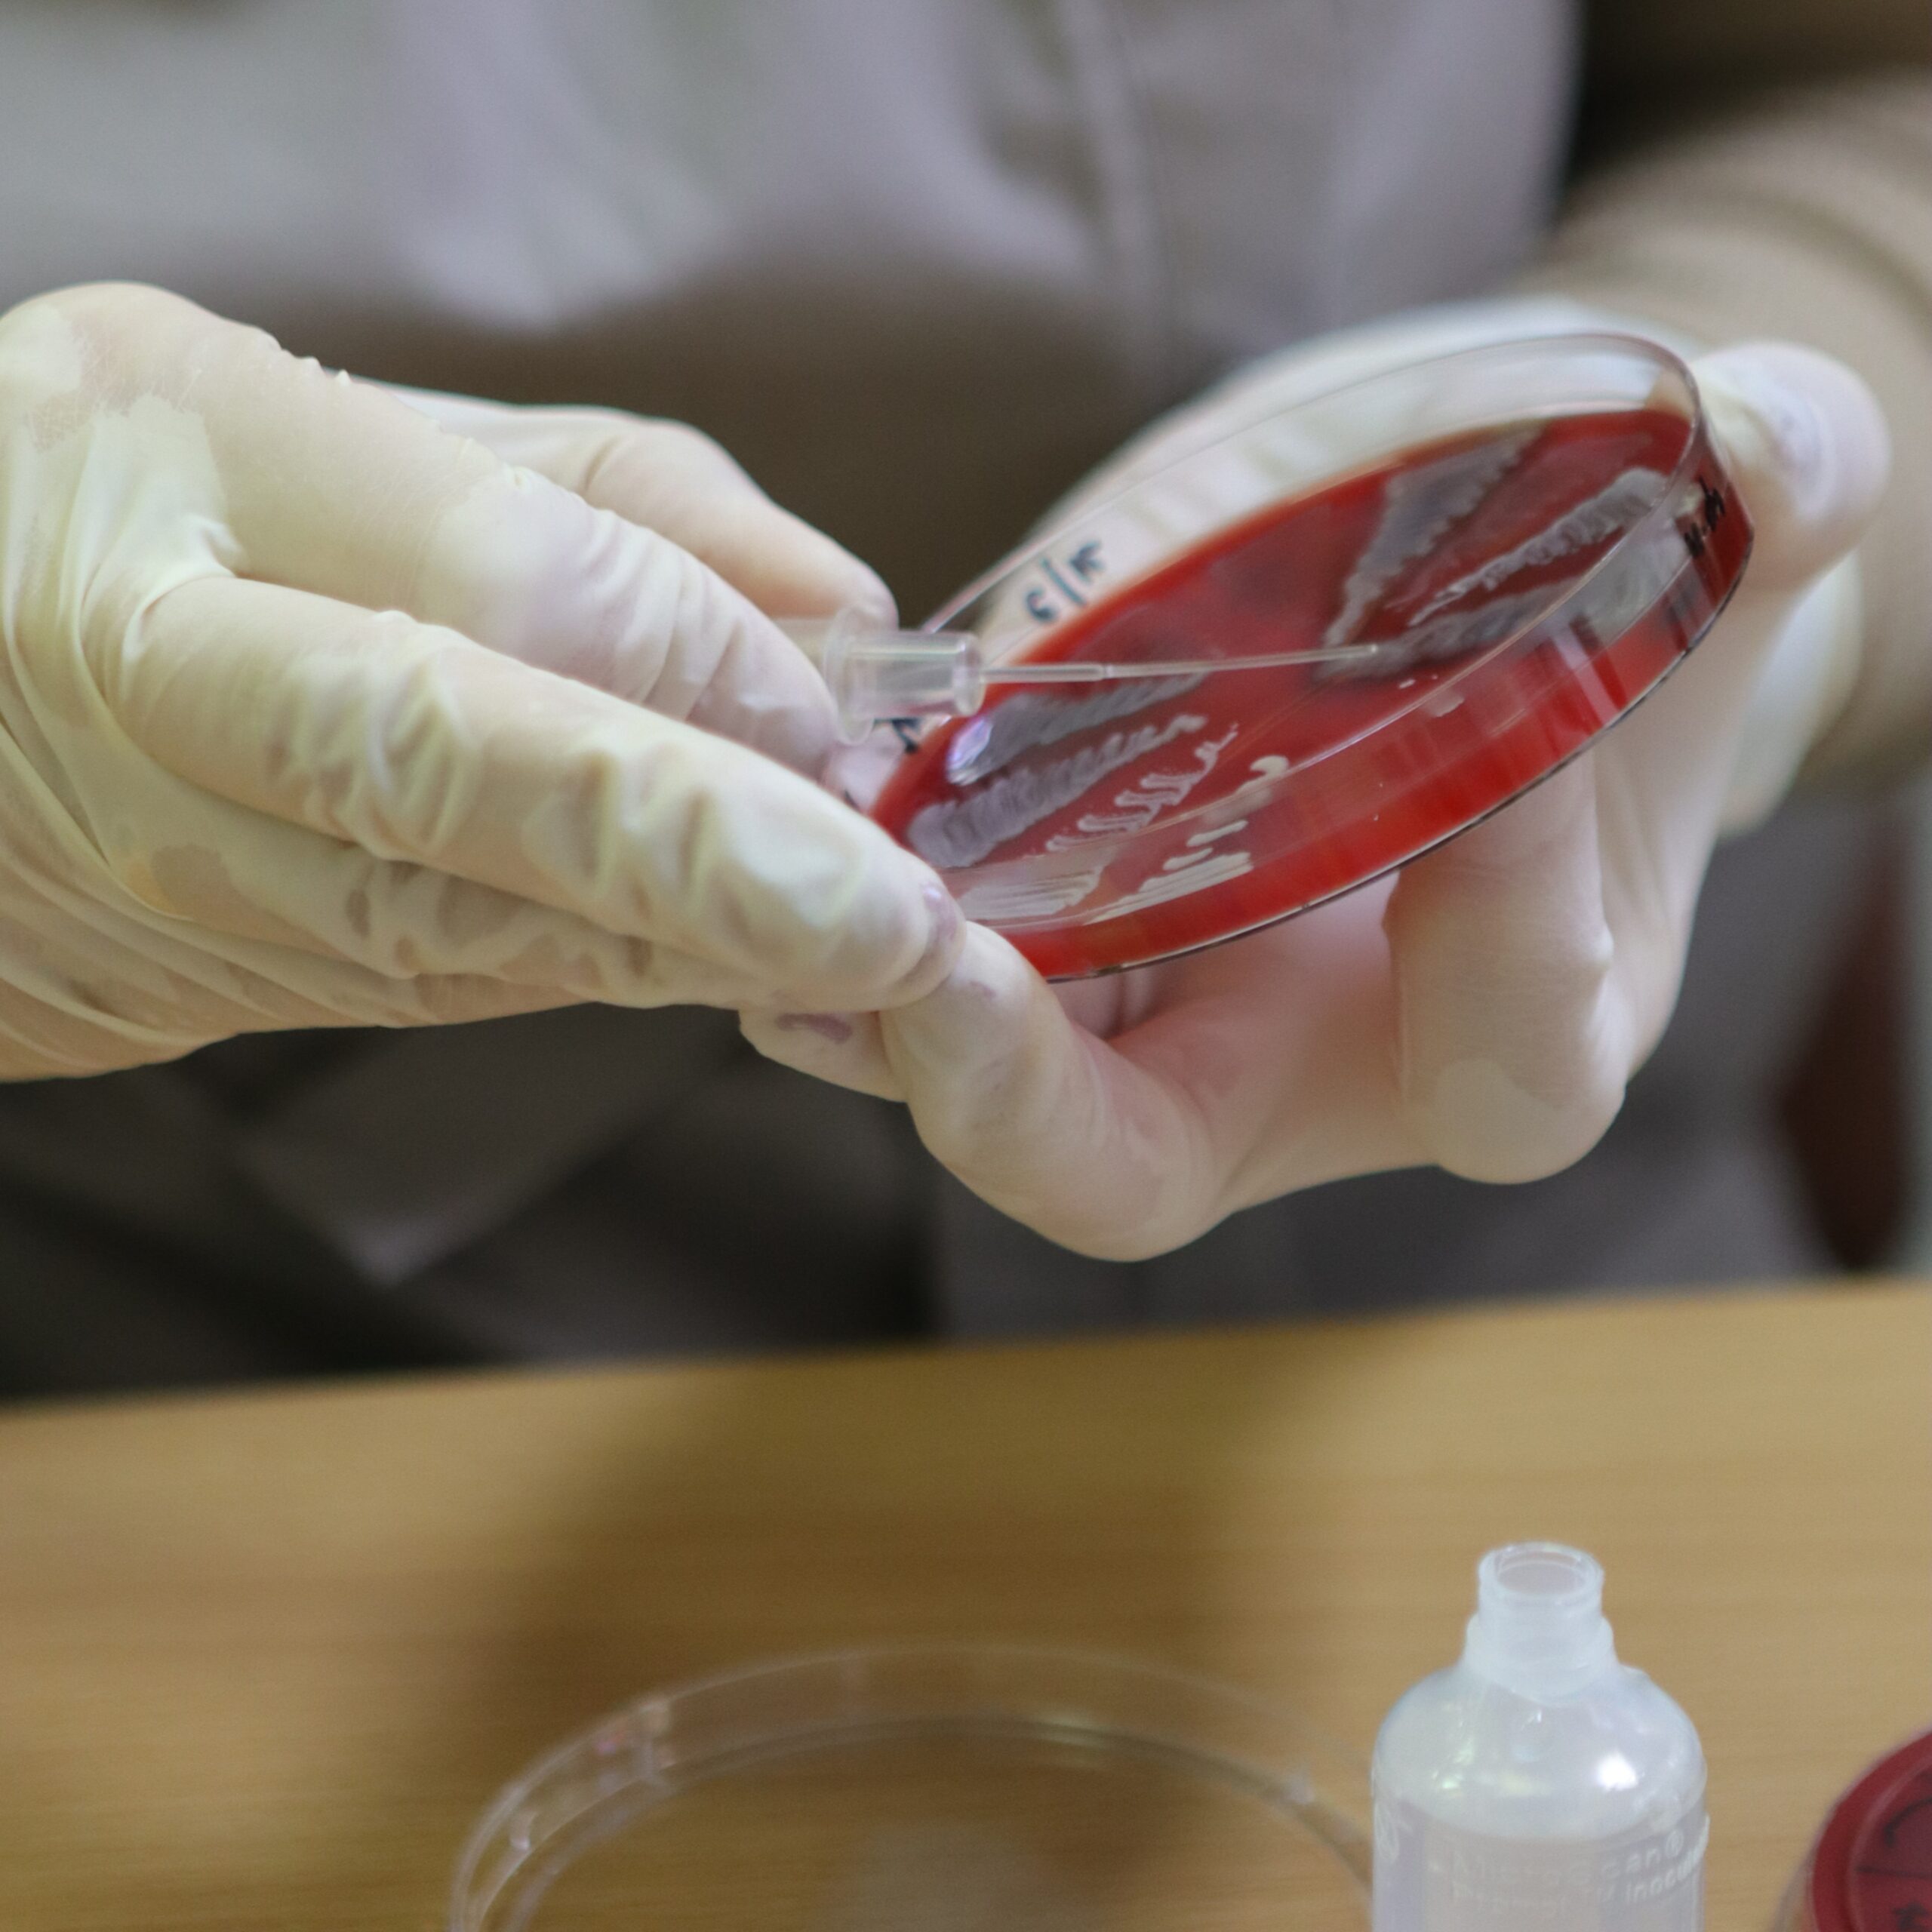
лабораторія

Київська обласна клінічна лікарня
Більше 160 років
на сторожі Вашого здоров’я
Наші відділення
Стаціонар
Поліклініка
Діагностика
Лабораторія
Невідкладна допомога

Стаціонар
ЧОМУ ВАРТО ЛІКУВАТИСЬ САМЕ У НАС?
На базі КОКЛ працюють кращі фахівці, які неодноразово підтверджували свій високий рівень підготовки, глибокі знання в медицині, професійні навички, рятуючи життя пацієнтам, що зневірились.
КОНСУЛЬТАТИВНО – ДІАГНОСТИЧНИЙ ЦЕНТР
ЦІНУЙТЕ ЧАС – ЗРОБІТЬ ПОПЕРЕДНІЙ ЗАПИС


ДІАГНОСТИКА
ЧОМУ ВАРТО ПРОЙТИ ОБСТЕЖЕННЯ У НАС?
Діагностичні обстеження Вам проведе досвідчений, висококваліфікований персонал
Постійнно впроваджуються новітні інноваційні методики
Ціна та якість завжди на вищому рівні
Новітнє обладнання гарантує точний результат
ЛАБОРАТОРІЯ
ЧОМУ САМЕ МИ?
Обладнання провідних світових виробників
Висококваліфікований персонал
Дієва система управління якістю
Більше ніж 300 видів аналізів
1-денний термін виконання більшості аналізів
Видаємо сертифікати дослідження міжнародного зразку
Результати аналізів українською, англійською, російською

РЕАНІМАЦІЯ
Відділення призначене для надання висококваліфікованої допомоги хворим з гострими невідкладними станами будь-якої етіології, а також інтенсивної післяопераційної терапії із застосуванням сучасних методів лікування та моніторингу.
Відділення оснащене сучасною апаратурою і функціональним обладнанням, необхідним для роботи з хворими, що знаходяться у важкому стані. Існує цілодобовий пост спостереження медичної сестри. Персонал відділення постійно контролює всі функції організму пацієнта. У будь-який час доби можуть проводитися необхідні лабораторні дослідження.

Об'єднання закладів охорони здоров’я Київщини
Структура Київської обласної клінічної лікарні
Основним завданням нашого підприємства є забезпечення кваліфікованої та доступної медичної допомоги для громадян. Наші спеціалісти зможуть надати високоякісну медичну допомогу на всіх етапах лікування та реабілітації.
ПРІОРИТЕТНІ НАПРЯМКИ
АРТРОСКОПІЧНІ ОПЕРАЦІЇ
Сучасні і ефективні артроскопічні операції в Київській обласній клінічній лікарні.
ІНСУЛЬТ
Інсульт — захворювання, яке є результатом раптового порушення мозкового кровопостачання.
ІНФАРКТ МІОКАРДА
Інфаркт міокарда — одне з найпоширеніших захворювань в кардіології.
СТОМАТОЛОГІЯ
Не забувайте, що існують такі поняття, як «прихований карієс», «підясенні камені» і «недоліковані канали», «кісти і гранульоми».
ЕНДОПРОТЕЗУВАННЯ СУГЛОБІВ
Ендопротезування тазостегнового або колінного суглоба іноді буває єдиним методом відновлення втраченої функції.
АКТУАЛЬНІ СТАТТІ ТА НОВИНИ
Куди і як поскаржитись на неправомірні дії
Як знайти заклад, який надає послуги з реабілітації амбулаторно
Безоплатні послуги для ВПО
Реабілітаційна допомога для ВПО
Велике об’єднання закладів охорони здоров’я Київщини
ЗАСІДАННЯ!
ПОДЯКА!
ПАЦІЄНТИ З МІННО-ВИБУХОВОЮ ТРАВМОЮ

Лабораторія
Наша лабораторія — це сучасний, потужний лабораторний комплекс, який оснащено обладнанням та реактивами виробництва відомих закордонних компаній.

ЗАВІДУВАЧІ ВІДДІЛЕНЬ
Найращі фахівці, які неодноразово підтверджували свій високий рівень підготовки, глибокі знання в медицині, професійні навички, рятуючи життя пацієнтам

НАЦІОНАЛЬНИЙ СКРИНІНГ ЗДОРОВ’Я 40+
КНП КОР «Київська обласна клінічна лікарня» приєднується до національної програми «Скринінг здоров’я 40+»
ЧОМУ НАМ ДОВІРЯЮТЬ

ЕКСПЕРТИ
Нам більше 160 років

ДОСТУПНІСТЬ

БАГАТОПРОФІЛЬНІСТЬ

АВТОРИТЕТНІСТЬ
Наші лікарі
Всі лікарі Київської обласної клінічної лікарні відповідають високим критеріям професіоналізму та майстерності в області діагностики і лікування різних захворювань.
Осадча Марина Євгенівна
Завідувачка аптечного відділення
Гордійчук Микола Прокопович
Завідувач відділення передпухлинних та пухлинних захворювань
Яценко Юлія Олегівна
Завідувачка центру ментального здоров’я
Росада Михайло Олексійович
Заступник медичного директора з інфекційного контролю
Ляпчук Ганна Ігорівна
Завідувачка відділу оцінювання повсякденного функціонування особи
Вінярська Ніна Василівна
Завідувачка відділення неврології
Андрусенко Ростислав Володимирович
Завідувач відділення післягострої та довготривалої реабілітації
Масуді Анна Василівна
Завідувачка відділення анестезіології, інтенсивної терапії екстракорпоральної детоксикації
Дубовий Ярослав Олександрович
Завідувач операційного відділення. Лікар-уролог
Архипенко Олександр Борисович
Завідувач відділу з інфекційного контролю
Зозуля Андрій Іванович
Завідувач центру кардіології та інтервенційної радіології
Винограденко Вікторія Іванівна
Завідувачка відділення ендоскопії
Черепанов Віктор Вікторович
Завідувач рентген-радіологічного вiддiлення
Васильєв Олександр Сергійович
Завідувач відділення щелепно-лицевої хірургії
Левицький Андрій Віталійович
Завідувач центру патології голови та шиї
Козачук Олександр Михайлович
Завідувач торакальної хірургії
Абраменко Артем Володимирович
Завідувач відділення судинної хірургії
Будько Тетяна Миколаївна
Завідувачка центру стаціонарної медичної допомоги
Снісаревський Павло Петрович
Завідувач патологоанатомічного відділення
Продусевич Лідія Володимирівна
Завідувачка Централізованої клініко-діагностичної лабораторії
Баюн Юрій Володимирович
Завідувач центру нейрохірургії
Марченко Наталія Володимирівна
в.о. Завідувачки відділення функціональної діагностики
Комарова Людмила Сергіївна
Завідувачка консультативно-діагностичного центру
Черняк Ольга Сергіївна
Завідувачка відділення ультразвукової діагностики
Герасімова Тетяна Петрівна
Завідувачка відділення офтальмології
Білик Світлана Давидівна
Завідувачка центру нефрології та діалізу
Горобець Костянтин Леонідович
Завідувач відділення реабілітації хворих з наслідками неврологічних захворювань та травм
Пироговський Володимир Юрійович
Завідувач проктологічного відділення
Яцик Ігор Михайлович
Завідувач центру хірургії, трансплантології та проктології
Корицький Андрій Вікторович
Завідувач урологічного відділення
Дудар Сергій Леонідович
Завідувач ортопедично-травматологічного центру.




























